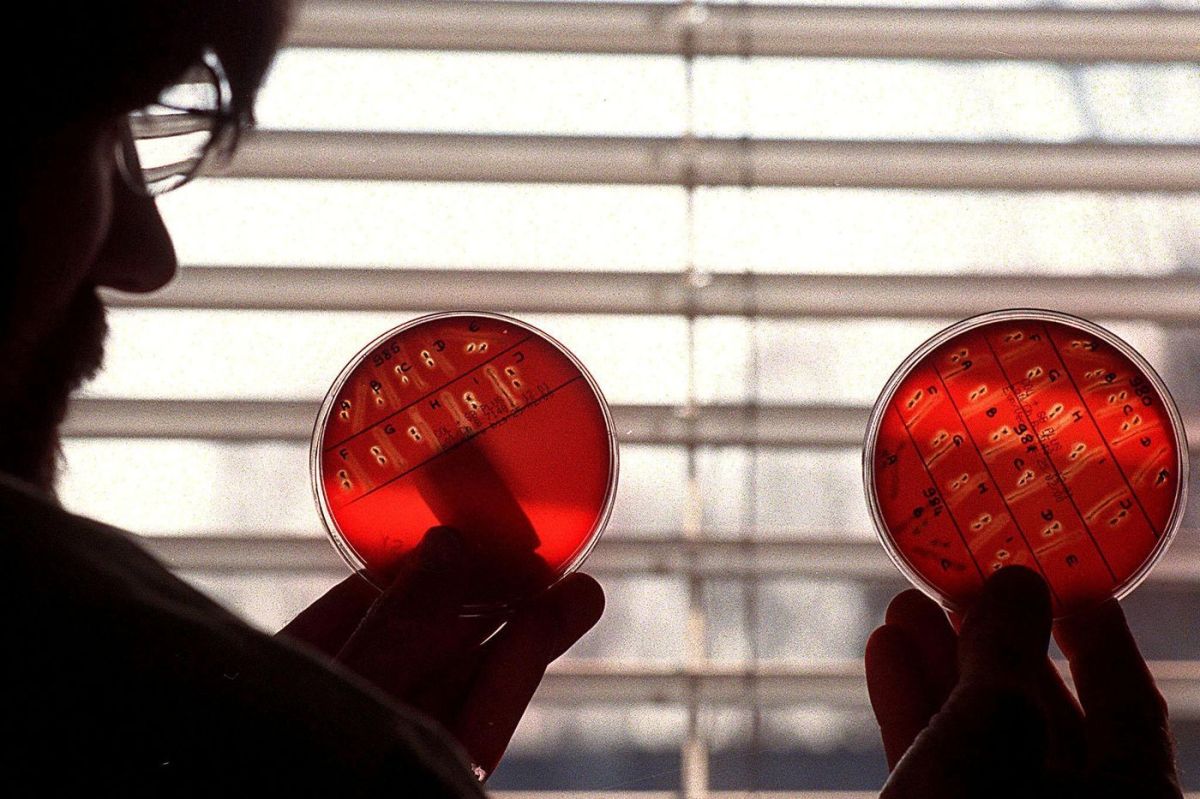
Listériose : une enquête judiciaire bouleverse le secteur de la charcuterie

Le parquet de Marseille a annoncé, le 23 mars, l'ouverture d'une information judiciaire pour « homicide involontaire » suite à des cas de listériose liés aux produits de charcuterie de l'entreprise Drôme Ardèche Tradition. Parmi les douze personnes touchées, deux ont tragiquement trouvé la mort.
Le parquet a précisé que cette enquête s'élargit également à d'autres charges, notamment « homicide involontaire par personne morale, blessures involontaires dues à une violation manifeste d’une obligation de sécurité, ainsi que mise en danger d’autrui ». Cette décision met en lumière des manquements potentiels à la sécurité alimentaire qui peuvent s'avérer dévastateurs.
Un arrêté préfectoral a été émis pour suspendre les activités de l'entreprise Drôme Ardèche Tradition et ordonner le retrait de tous les produits concernés. Ce retrait se fait « sous la supervision des services de l’État », comme l'a confirmé le ministère de la Santé et de l'Agriculture le 12 mars dernier.
Le parquet de Marseille, qui est l'un des pôles de santé publique en France, a la responsabilité de traiter ce type d'affaires, ayant compétence sur plusieurs régions, dont la Drôme.
Quelques dizaines de décès par an
Parmi les douze cas identifiés, sept étaient survenus en janvier, et l'âge médian des personnes infectées était de 81 ans, la majorité étant des personnes âgées de plus de 65 ans. Deux des victimes, âgées de plus de 75 ans et ayant des comorbidités, sont décédées.
Les produits en question comprennent des caillettes, des pâtés en croûte et d'autres charcuteries commercialisées entre le 17 janvier et le 28 février, souvent sous les marques « Drôme salaisons » et « Jules Courtial ».
La bactérie Listeria monocytogenes est responsable de la listériose, qui est la seconde cause de mortalité due à des intoxications alimentaires en France, juste après les salmonelles, qui causent plusieurs centaines de décès chaque année.
La période d'incubation de cette infection dure généralement d'une à deux semaines, mais peut parfois aller jusqu'à trois mois. Les femmes enceintes, à risque accru, peuvent avoir jusqu'à vingt fois plus de chances de développer cette maladie. La listériose se traite principalement avec des antibiotiques.